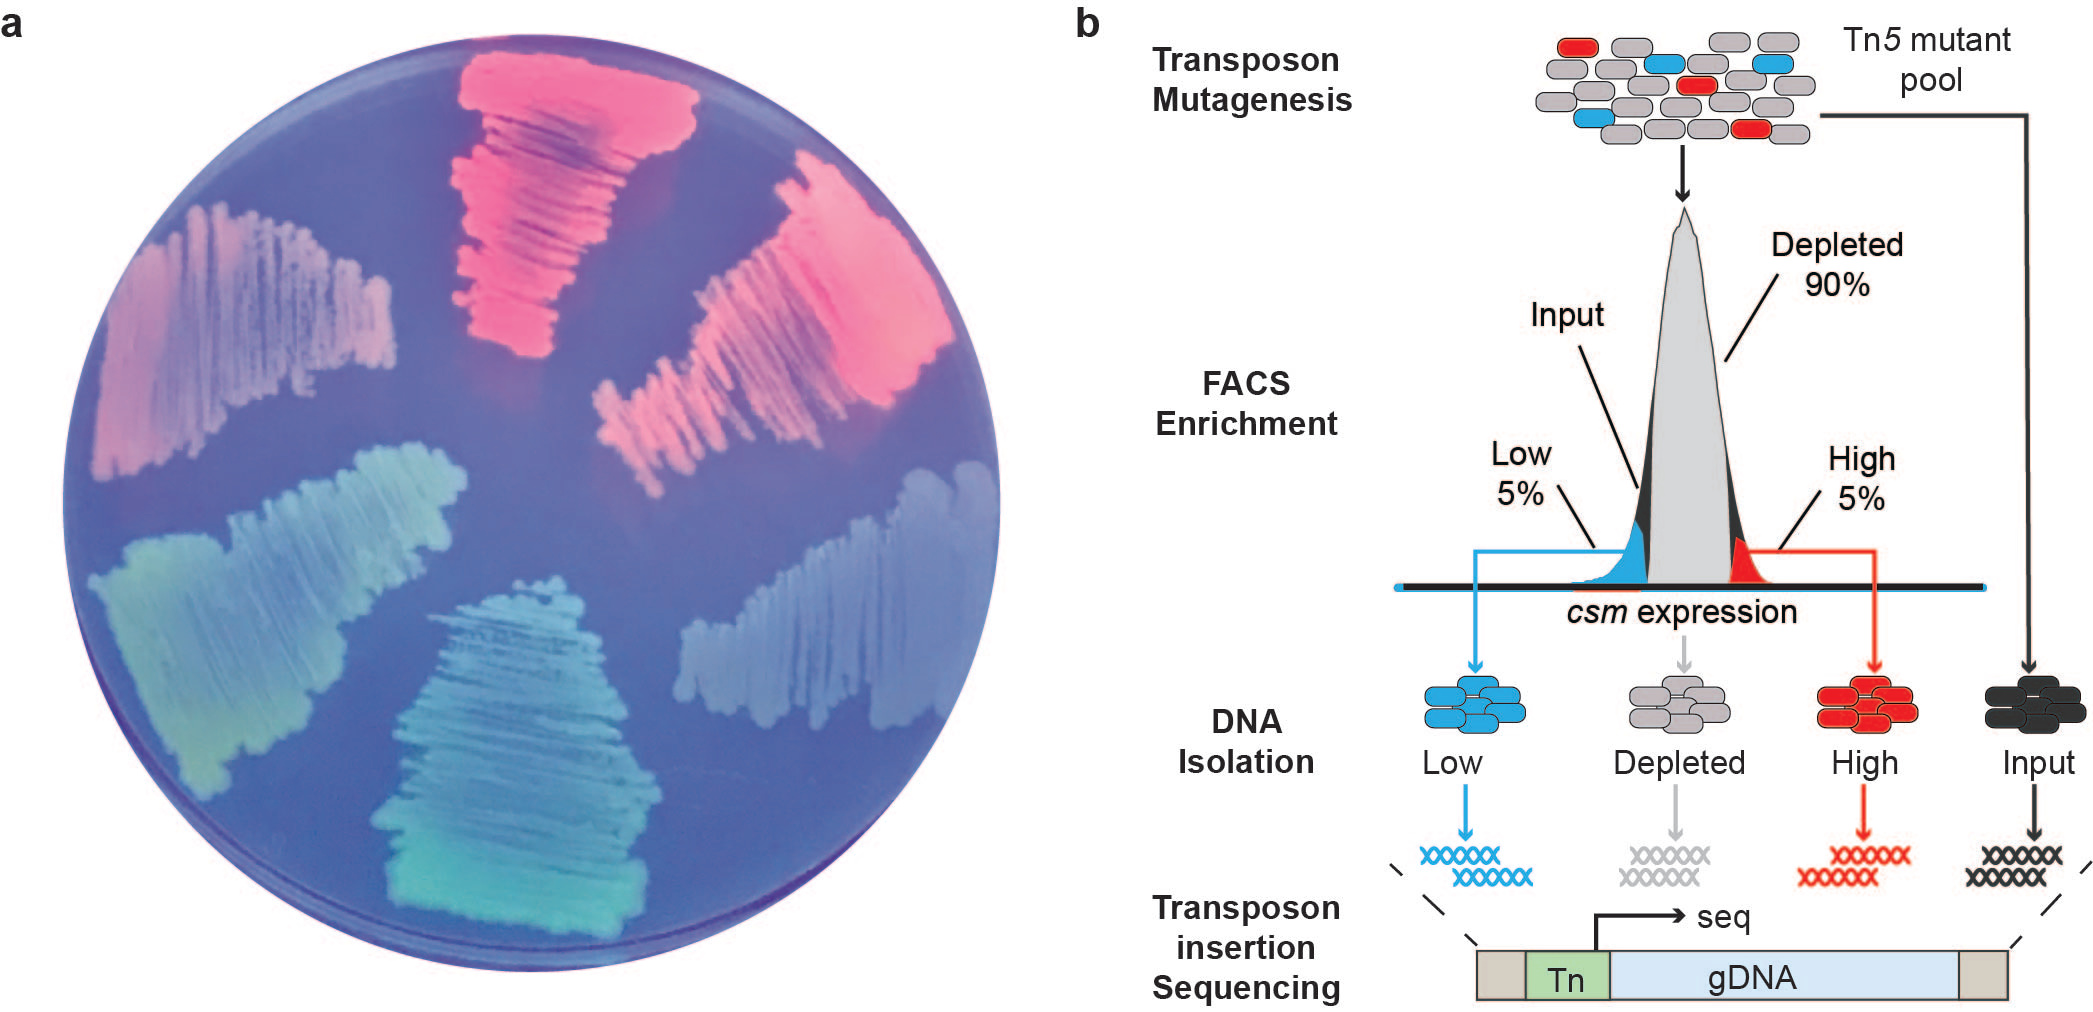

Inverse regulation of CRISPR-Cas and surface-based immunity discriminates plasmids versus phages
Published in Microbiology
Bacteria have a evolved a multitude of defenses during their arms-race with bacteriophages (phages)1 and other mobile genetic elements. These defenses include innate mechanisms, such as abortive infection and cell surface modification, and adaptive defense via CRISPR-Cas. Our recent study2 explores how bacteria regulate CRISPR-Cas defense. Immune systems can carry costs to the host3; therefore, depending on cellular conditions, certain innate or adaptive defenses may be favored.
Our aim was to systematically uncover CRISPR-Cas regulators using a non-biased, genome-wide approach. While many transposon-based methods exist, we were surprised at the lack of suitable screens to identify regulators of gene activity. To address this, we developed a new high-throughput method called SorTn-seq (pronounced ‘sort ‘n seek’) which utilizes fluorescence-activated cell sorting (FACS) to isolate mutants with altered cas promoter activity from within a complex transposon mutant pool (Figure 1). Mutants are then deep sequenced to identify transposon sites and identify regulators. Shortly after we started work on SorTn-seq, a study4 showed a transposon mutant pool could be sorted based on accumulation of intracellular ethidium bromide to identify drug efflux pathways. This gave us confidence that our idea to study gene regulatory networks by sorting and sequencing hundreds of thousands of mutants based on altered fluorescent reporter activity wasn’t totally crazy!
Figure 1. SorTn-seq in Serratia. (a) Different fluorescent reporters were screened for suitability, then fused with the promoter of the type III-A CRISPR-Cas system. (b) Cells were then mutated and sorted based on fluorescence levels, followed by deep sequencing to locate transposon insertion sites, and identify putative regulators (adapted from Smith et al., 2021).
We applied SorTn-seq in Serratia sp. ATCC 39006 to find type III-A CRISPR-Cas regulators. Excitingly, our technique allowed us to screen a library of ~300,000 unique transposon mutants in approximately two hours! For context, a previous manual screen of 10,000 transposon mutants for changes in LacZ activity took more than 6 months to complete. Using this approach, we identified several signaling pathways and regulators that alter csm (cas operon) expression, including metabolic and motility regulators and stress response systems.
Interestingly, several mutations conferring low csm expression activate the Rcs (regulator of capsular polysaccharide synthesis) stress response pathway, which monitors outer membrane, periplasmic, peptidoglycan, and lipopolysaccharide integrity5. Our results show that activation of this stress response decreased CRISPR-Cas expression, targeting (interference) and spacer acquisition (adaptation) by all three systems in this strain (type III-A, type I-E and type I-F).
Because Rcs-activation led to reduced CRISPR-Cas defense against plasmids, we wanted to investigate its effect on phage infection as well. We screened different Rcs-activating mutants against four unrelated Serratia phages and, to our surprise, phage infection was inhibited. We then discovered that abrogation of phage infectivity was due to downregulation of genes encoding phage receptors. Thus, activation of the Rcs pathway concomitantly controls adaptive and surface-based immunity in response to cell stress.
Why would cells turn down CRISPR-Cas immunity during times of stress? Interestingly, Rcs activation is triggered by antibiotics, particularly β-lactams. We hypothesize that during antibiotic exposure, downregulation of CRISPR-Cas defense may allow cells to uptake potentially beneficial traits from the environment (e.g. antibiotic resistance genes), allowing them to adapt to stressors. Indeed, previous work has shown that CRISPR-Cas mutants can arise during selection for antibiotic resistance genes6. During Rcs-activation, the simultaneous increase in surface-based immunity also keeps the threat of phage infection low, thus balancing horizontal gene transfer with phage defence (Figure 2). Our work provides a widely applicable new method to study gene regulation in bacteria and uncovers how innate and adaptive immunity can be coordinately regulated to allow cells to discriminate horizontal gene transfer from detrimental phages.

Figure 2. Model of Rcs-mediated switching between CRISPR-Cas and surface-based immunity in response to cell stress. Adapted from Smith et al., 2021.
References
1 Hampton, H. G., Watson, B. N. J. & Fineran, P. C. The arms race between bacteria and their phage foes. Nature 577, 327-336, doi:10.1038/s41586-019-1894-8 (2020).
2 Smith, L. M. et al. The Rcs stress response inversely controls surface and CRISPR–Cas adaptive immunity to discriminate plasmids and phages. Nature Microbiology, doi:10.1038/s41564-020-00822-7 (2021).
3 van Houte, S., Buckling, A. & Westra, E. R. Evolutionary Ecology of Prokaryotic Immune Mechanisms. Microbiol. Mol. Biol. Rev. 80, 745-763, doi:10.1128/MMBR.00011-16 (2016).
4 Hassan, K. A. et al. Fluorescence-Based Flow Sorting in Parallel with Transposon Insertion Site Sequencing Identifies Multidrug Efflux Systems in Acinetobacter baumannii. mBio 7, doi:10.1128/mBio.01200-16 (2016).
5 Wall, E., Majdalani, N. & Gottesman, S. The Complex Rcs Regulatory Cascade. Annu. Rev. Microbiol. 72, 111-139, doi:10.1146/annurev-micro-090817-062640 (2018).
6 Jiang, W. et al. Dealing with the evolutionary downside of CRISPR immunity: bacteria and beneficial plasmids. PLoS Genet. 9, e1003844, doi:10.1371/journal.pgen.1003844 (2013).
Follow the Topic
-
Nature Microbiology
An online-only monthly journal interested in all aspects of microorganisms, be it their evolution, physiology and cell biology; their interactions with each other, with a host or with an environment; or their societal significance.
Related Collections
With Collections, you can get published faster and increase your visibility.
The Clinical Microbiome
Publishing Model: Hybrid
Deadline: Mar 11, 2026
Please sign in or register for FREE
If you are a registered user on Research Communities by Springer Nature, please sign in